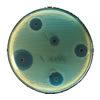
virus alimentos

Gestionar correctamente el control de la bacteria Listeria monocytogenes es tan necesario como complejo. Los brotes de listeriosis son posibles, trazables y con consecuencias reales, tanto para la salud pública como para las empresas involucradas. Conocer bien la ecologia de la Listeria e identificar las medidas de control más efectivas en cada entorno es fundamental para proteger al consumidor.
Gestionar correctamente el control de la bacteria Listeria monocytogenes es tan necesario como complejo. Los brotes de listeriosis son posibles, trazables y con consecuencias reales, tanto para la salud pública como para las empresas involucradas. Conocer bien la ecologia de la Listeria e identificar las medidas de control más efectivas en cada entorno es fundamental para proteger al consumidor.

 La jornada técnica A la vanguardia en seguridad alimentaria: Campylobacter, bacteriófagos y metagenómica, organizada por
La jornada técnica A la vanguardia en seguridad alimentaria: Campylobacter, bacteriófagos y metagenómica, organizada por  Este documento, promovido por la Asociación de mataderos de aves y conejos de Cataluña (ASSOCAT) y reconocido oficialmente por las autoridades catalanas en materia de seguridad alimentaria, facilita la aplicación de los distintos sistemas de autocontrol, teniendo en cuenta todas las realidades de los mataderos de aves de corral en Cataluña.
Este documento, promovido por la Asociación de mataderos de aves y conejos de Cataluña (ASSOCAT) y reconocido oficialmente por las autoridades catalanas en materia de seguridad alimentaria, facilita la aplicación de los distintos sistemas de autocontrol, teniendo en cuenta todas las realidades de los mataderos de aves de corral en Cataluña. La industria agroalimentaria produce gran cantidad de residuos, a partir de los cuales es posible desarrollar bioplásticos, con las mismas características que los plásticos convencionales pero mucho más sostenibles medioambientalmente. Estos nuevos materiales se reutilizan, en muchos casos, en la propia industria alimentaria, lo que cierra su ciclo de vida útil con una huella de carbono mucho menor.
La industria agroalimentaria produce gran cantidad de residuos, a partir de los cuales es posible desarrollar bioplásticos, con las mismas características que los plásticos convencionales pero mucho más sostenibles medioambientalmente. Estos nuevos materiales se reutilizan, en muchos casos, en la propia industria alimentaria, lo que cierra su ciclo de vida útil con una huella de carbono mucho menor. Directamente relacionadas con la seguridad alimentaria, la higiene y la limpieza son elementos indispensables para garantizar un buen funcionamiento de los establecimientos de hostelería. Una mayor exigencia en materia de higiene en las cocinas colectivas es la tendencia que marca la sociedad actual y el reto para los profesionales del sector. Pero, ¿cuáles son los principales puntos críticos al higienizar una cocina?
Directamente relacionadas con la seguridad alimentaria, la higiene y la limpieza son elementos indispensables para garantizar un buen funcionamiento de los establecimientos de hostelería. Una mayor exigencia en materia de higiene en las cocinas colectivas es la tendencia que marca la sociedad actual y el reto para los profesionales del sector. Pero, ¿cuáles son los principales puntos críticos al higienizar una cocina? La
La  La consultoría internacional Mintel, especializada en investigación, análisis e inteligencia de mercado, ha publicado un estudio acerca de doce tendencias clave que impactaran sobre el mercado global de alimentación y bebidas para 2016.
La consultoría internacional Mintel, especializada en investigación, análisis e inteligencia de mercado, ha publicado un estudio acerca de doce tendencias clave que impactaran sobre el mercado global de alimentación y bebidas para 2016.
 El objetivo del
El objetivo del  La versión 7 de la norma internacional BRC Food Safety empezó a aplicarse el pasado mes de julio en las auditorías de seguridad alimentaria e higiene. ¿Cuales son los cambios clave respecto a la versión anterior? John Kukoly, responsable de las normas BRC en América, lo explica.
La versión 7 de la norma internacional BRC Food Safety empezó a aplicarse el pasado mes de julio en las auditorías de seguridad alimentaria e higiene. ¿Cuales son los cambios clave respecto a la versión anterior? John Kukoly, responsable de las normas BRC en América, lo explica.